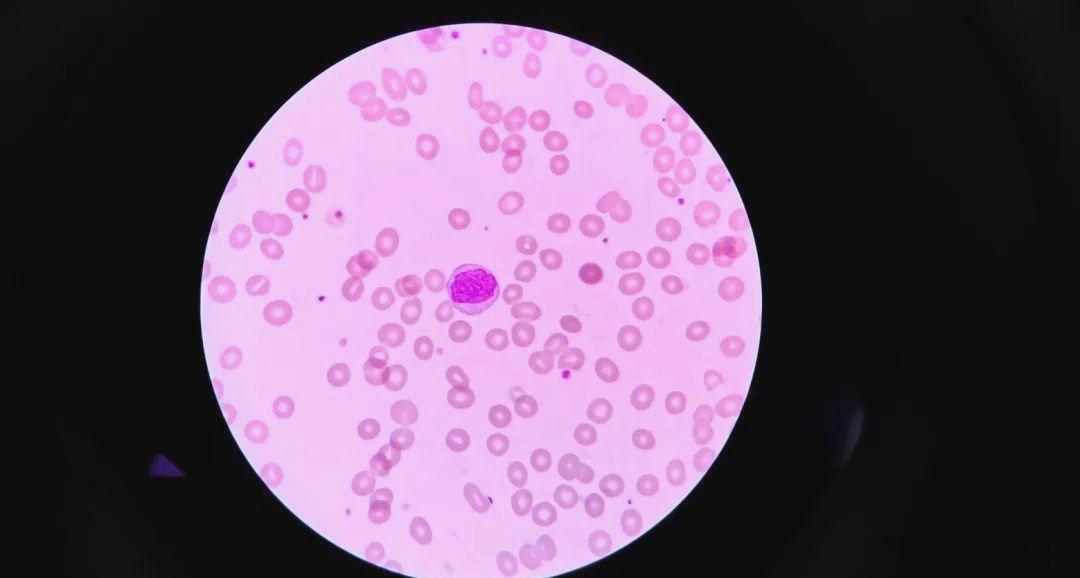
原幼单核细胞形态与诊断之间的微观探索
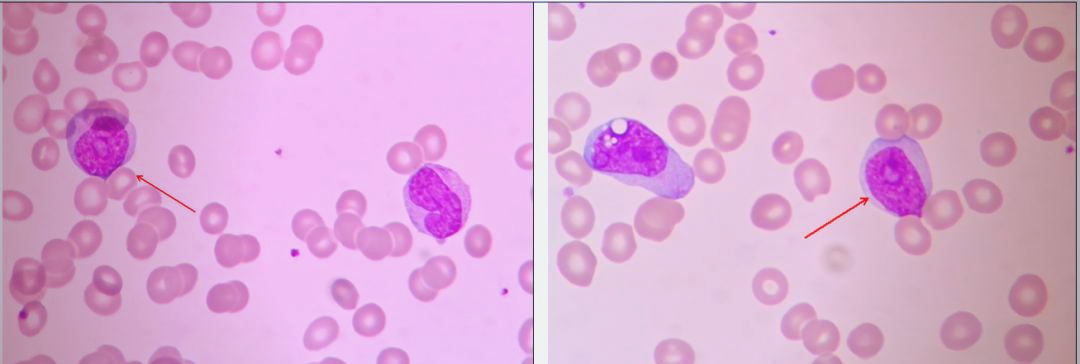
原幼单核细胞形态与诊断之间的微观探索
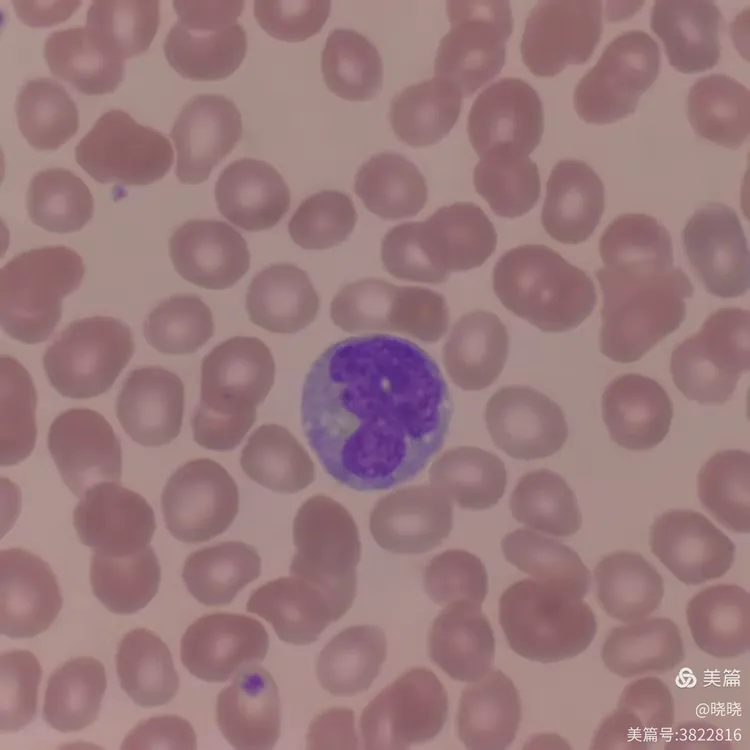
第一次见幼稚单核细胞
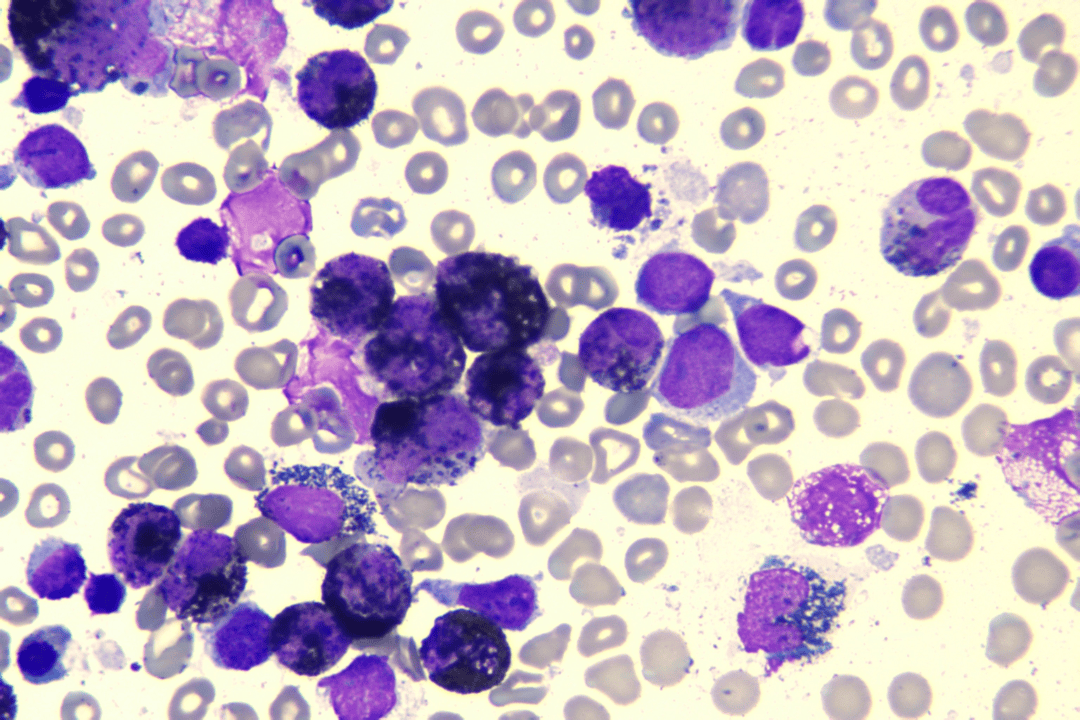
儿童单核细胞增高原因探索
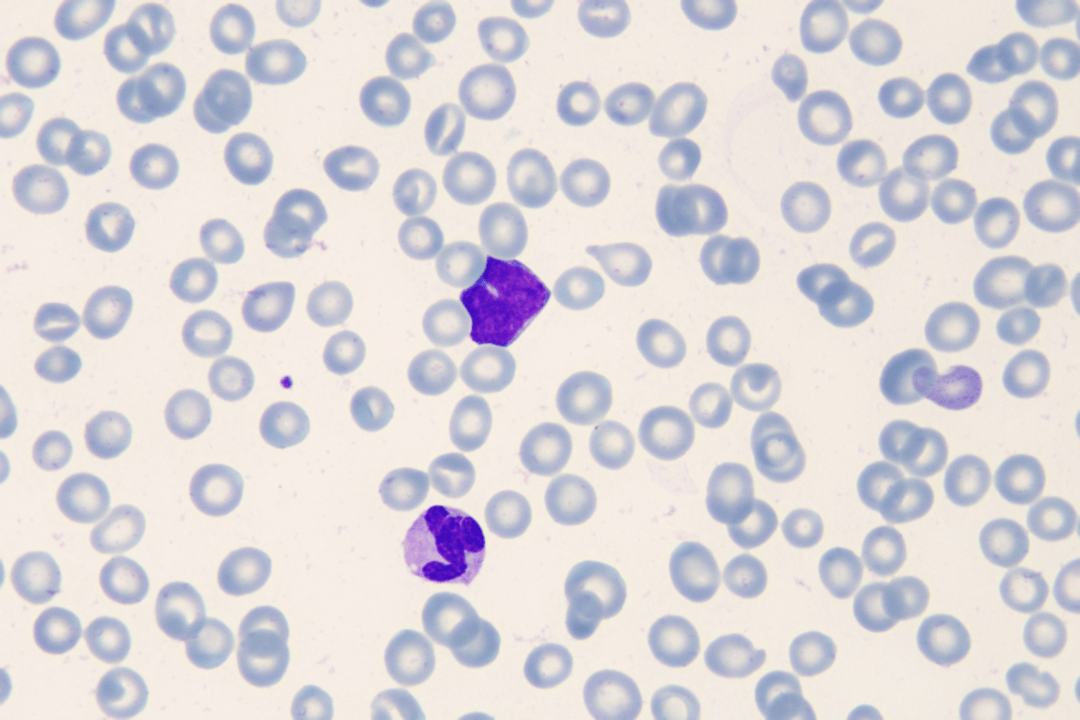
儿童单核细胞增高原因探索

幼单核细胞图片

🔬探索单核细胞的奥秘
图片尺寸1067x1067
幼单核细胞
图片尺寸890x768
原幼单核细胞形态学介绍
图片尺寸1024x574
原幼单核细胞形态与诊断之间的微观探索
图片尺寸1080x372
幼稚单核细胞.细胞胞体圆形或不规则形;胞质丰富,灰蓝色或蓝色
图片尺寸1175x783
🔬 探索幼稚单核细胞的世界 🌍
图片尺寸802x772
仔细观察:单核细胞形态
图片尺寸1072x861
原幼单核细胞形态与诊断之间的微观探索
图片尺寸1080x578
单核细胞
图片尺寸1948x2560
从早动红细胞到晚幼红细胞,再到中幼红细胞,最后到正色素
图片尺寸1080x1525
单核细胞
图片尺寸2013x2560
原幼单核细胞形态与诊断之间的微观探索
图片尺寸1080x364
第一次见幼稚单核细胞
图片尺寸750x750
幼稚单核细胞
图片尺寸650x484
🔬医学检验形态学:单核细胞揭秘🔍
图片尺寸951x1218
🔬医学检验形态学:单核细胞揭秘🔍
图片尺寸951x1218
🔬探索单核细胞的奥秘
图片尺寸1088x1050
儿童单核细胞增高原因探索
图片尺寸1080x720
儿童单核细胞增高原因探索
图片尺寸1080x720
儿童单核细胞增高原因探索
图片尺寸1080x720